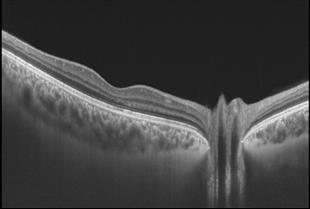

פרופסור אבינועם אופיר
- תחומים: עיניים , חוות דעת משפטית , רשתית , גלאוקומה , OCT - OCTA
 פרופסור אבינועם אופיר
פרופסור אבינועם אופירמרפאות
- קליניקה פרטית, סוקולוב 81, קומה 3, רמת השרון
אודות פרופסור אבינועם אופיר
פרופ' אבינועם אופיר, מומחה למחלות עיניים. בעבר ניהל את יחידת העיניים בבית החולים "הלל-יפה" בחדרה. קודם לכן – לימודי רפואה, התמחות ברפואת עיניים ורופא בכיר ב"הדסה" עין- כרם, ירושלים
שטחי עיסוק עיקריים של פרופ' אופיר:
גלאוקומה, רשתית, זגוגית וOCT-. במרפאה קיים מכשור לבדיקת OCT ובדיקת OCTA.
יועץ-על, "מכבי" שרותי בריאות. המרפאה הפרטית של פרופ' אבינועם אופיר מכבדת ביטוחים מחברות הביטוח השונות במסלול החזר.
בין פריצות הדרך והחידושים העולמיים של פרופ' אופיר במחלות וניתוחי הרשתית והגלאוקומה:
רשתית:
א) הבצקת הסוכרתית ברשתית העין: אבחון הגורם המרכזי להיווצרות בצקת המקולה (= הצטברות נוזלים במרכז הראייה ברשתית) בחולי סוכרת (משנת 2010). חיזוק לממצאים אלה והוכחות קליניות הופיעו בהדרגה במשך השנים. מאמר-מערכת עדכני פורסם ב-2024: Ophir A. Long-lasting pathogenesis-related drying of diabetic macular edema. The European Society of Medicine. 2024;12(11) [online].
עשרות מיליונים חולי סוכרת ברחבי העולם סובלים מבצקת זו, המהווה את הסיבה העיקרית לפגיעה בראיה בחולי הסוכרת. בניגוד לטיפול בבצקת זו בזריקות לתוך העין במשך שנים, הוכחנו בעזרת הדמיית OCT בתלת-מימד כי הגורם העיקרי לבצקת הינו מכני: משיכת המקולה ע"י קרומי זגוגית העין הסמוכים לרשתית והנמצאים במרחק של עד מספר מ"מ ממרכז המקולה (extrafoveal); ממצא זה לא מאובחן בבדיקת OCT סטנדרטית. כך נמצא שניתוח בודד להסרת משיכות הזגוגית (ניתוח "ויטרקטומי"), בעיניים "נאיביות", כלומר בעיניים שלא טופלו בזריקות בעבר, השיג ייבוש מלא וארוך טווח של המקולה ב-92-100% מהמחקרים.

ב) אבחון מנגנון מרכזי הגורם לבצקת במקולה לאחר חסימה וורידית ברשתית, לאחר ניתוחי קטרקט, ועוד (2010-11).
ג) מחקר מעבדתי למציאת תרופה למניעת נזק ברשתית לאחר חסימה עורקית זמנית. נרשם כפטנט ב"הדסית", "הדסה" עין-כרם (1994) .
גלאוקומה:
א) גילוי התרופה FU-5, המוזרקת לדופן העין למניעת הצטלקות בלתי-רצויה לאחר ניתוחי עיניים (1982). טיפול זה לעין נמצא בשימוש קבוע בעולם מ-1984, ובעיקר בניתוחי גלאוקומה. כאשר נחסם ניקוז הנוזל מהעין, ונוזל חדש ממשיך להצטבר בעין, עולה הלחץ התוך-עיני ונוצרת מחלת הגלאוקומה שיכולה לגרום לעיוורון. כאשר לא עוזר הטיפול בתרופות השונות ו/או בלייזר להורדת הלחץ, מתבקש ניתוח בו יוצרים פתח פנימי חדש בעין למטרת ניקוז תקין. אולם מכיון שצלקת נוצרת באופן טבעי בגוף לאחר פתיחה של רקמה, הכשלון הניתוחי בגלאוקומה היה גבוה מאד עקב היווצרות שכיחה של צלקת וסתימה של הפתח החדש. כתוצאה מכך אובדן הראיה בחולי גלאוקומה היה שכיח. במחקרנו זיהינו את התרופה כיעילה ובטוחה בעין במינון מתאים. הטיפול ב--FU 5 בעת הניתוח ואחריו נמצא מהפכני: הוכח כי מתן התרופה מונע את תהליך ההצטלקות והסתימה של הפתח החדש שנוצר. ע"י כך נשמרת ההצלחה הניתוחית וחדות הראיה. כיום קיים גם "דור שני" לתרופה-FU 5, והוא מיטומיצין; לעיתים משתמשים בשתיהן.
ב) הוכחה כי-FU 5 פוגע בתאי ההצטלקות (מיופיברובלסטים) ישירות ולא רק מונע התרבותם (1992). הישימות – חשובה מאד מבחינה פרקטית.
ג) הסבר מנגנון ההידקקות ועד פריצה (פרפורציה) של בועת הסינון לאחר ניתוחי גלאוקומה בעקבות טיפול במיטומיצין, ומניעתו (2007). קודם לכן היה זה הסיבוך העיקרי של מיטומיצין בניתוחי גלאוקומה.
ד) שיטה חדשנית ויעילה מאד ל-Needling של בועת הסינון (2002).
ה) האבחון המוקדם ביותר של מחלת הגלאוקומה באמצעות בדיקת ההדמיה המאד-מדויקת, OCT (2010, 2003). גישה זו הפכה קבועה בעולם. לשם אבחון מדויק של גלאוקומה וגם באבחון בשינויים במשך תקופת המעקב יש צורך בבדיקת ראש עצב הראיה ב- OCT. הדיוק מונע טיפולים מוקדמים מיותרים, ולחילופין – מלמד על המועד הנדרש לתחילת הטיפול ועל צורך בשינוי בטיפול בעת המעקב.
אחרים:
א) אבחון לראשונה של מחלה נוירולוגית (פרקינסון) בעיניים באמצעות בדיקת ההדמיה OCT (2004). לאחר מכן הפך השימוש ב- OCT בעיניים כעזר משמעותי באבחון ומעקב-טיפולי במחלות נוירולוגיות שונות.
ב) אבחון של בצקת עצב הראייה (פפילאדמה) לעומת פסוידופפילאדמה באמצעות OCT (2005); החשיבות הקלינית רבה.
ג) ועוד..
- שירות ניתן בשפות:
אנגלית
גרמנית
עברית


 חיפוש רופאים
חיפוש רופאים  בדיקות
בדיקות  מונחים
מונחים  כתבות ומחקרים
כתבות ומחקרים  ערוצי תוכן
ערוצי תוכן  מחשבונים
מחשבונים

מאת: פרופ' אבינועם אופיר
מאת: פרופ' אבינועם אופיר 


